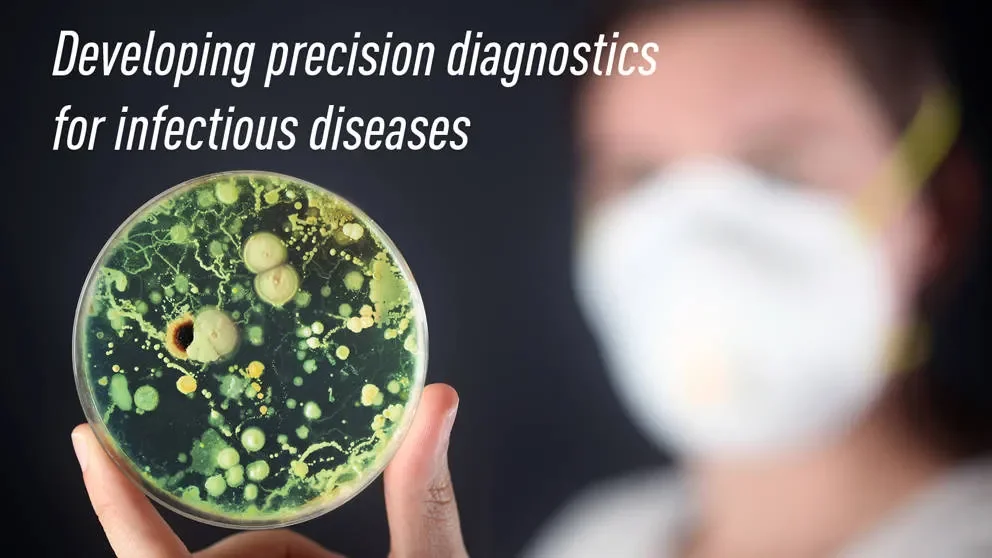
The Jackson Laboratory and bioMérieux to develop precision diagnostics for infectious diseases

The Jackson Laboratory and bioMérieux to develop precision diagnostics for infectious diseases
Article | August 30, 2016
The Jackson Laboratory (JAX) has entered into a sponsored research agreement with bioMérieux USA to develop more precise diagnostics for pathogens and their antimicrobial resistances in infectious diseases.
BioMérieux is a multinational biotech company, headquartered in France, specializing in in vitro diagnostics for infectious diseases. They will work with the laboratory of George Weinstock, Ph.D., JAX professor, Evnin Family Chair and director of microbial genomics.
Under the research agreement, JAX and bioMérieux will seek better methods to identify individuals at risk for infection, the pathogens that cause an individual’s infection, and which antibiotics offer the most effective treatment for the patient.
“Our laboratory brings expertise in next-generation DNA sequencing and metagenomic analysis, which is transforming our ability to bring precision medicine to infectious diseases,” Weinstock says. “BioMérieux brings a wealth of expertise in clinical microbiology and the biology and detection of microbial resistance, all critical factors in determining the right antibiotic treatment for a given infection.”
Weinstock notes that infectious disease research is relatively new to The Jackson Laboratory, “but the fact that we are now collaborating with a major diagnostics company shows that there’s a very bright future for this research in Connecticut, a future made possible by the state’s investment in JAX Genomic Medicine.”
“We have had a long informal working relationship with Dr. Weinstock, starting while he was at Washington University School of Medicine and now in his new role at JAX, says bioMérieux Science Office Vice President William Michael Dunne, Ph.D. “I look forward to working with him under this new formalized framework, where I believe some very novel and exciting approaches toward diagnostic microbiology will emerge.”
The Jackson Laboratory is an independent, nonprofit biomedical research institution based in Bar Harbor, Maine, with a National Cancer Institute-designated Cancer Center, a facility in Sacramento, Calif., and a genomic medicine institute in Farmington, Conn. It employs 1,800 staff, and its mission is to discover precise genomic solutions for disease and empower the global biomedical community in the shared quest to improve human health.
